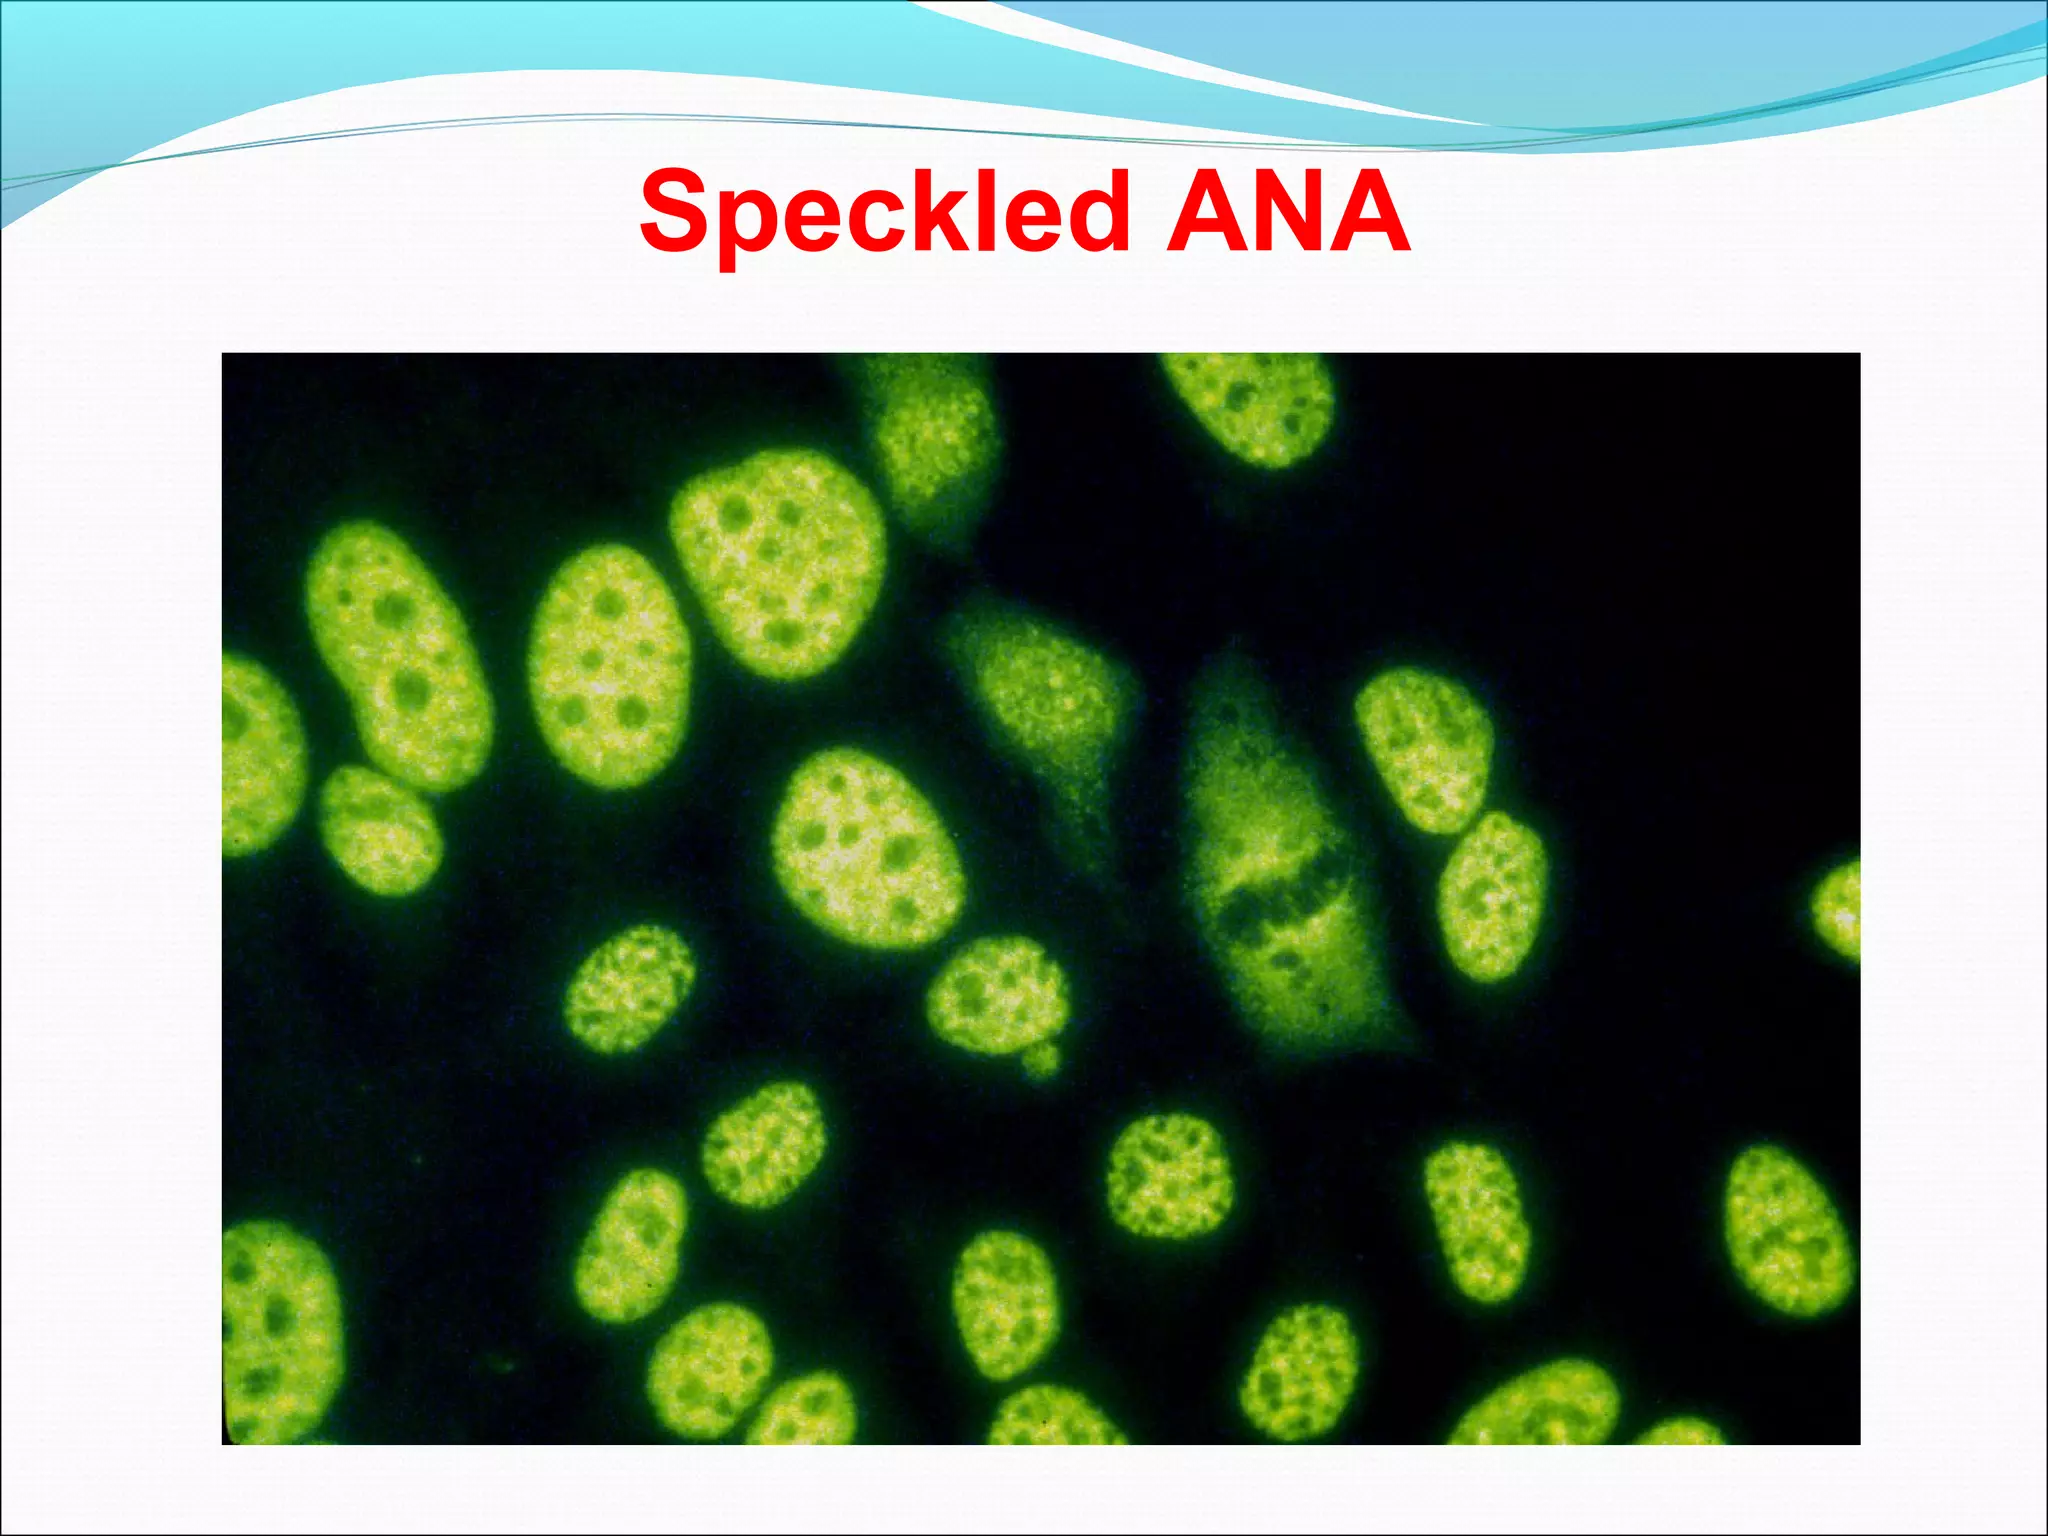
Speckled ANA

The document provides an overview of connective tissue diseases, focusing on systemic lupus erythematosus (SLE) and rheumatoid arthritis, including their symptoms, diagnostic criteria, and treatment options. It highlights the autoimmune nature of these conditions, their prevalence, and various clinical manifestations affecting different organ systems. Additionally, the document discusses related syndromes like Sjögren's syndrome and the importance of differentiating these diseases based on specific autoimmune markers and clinical features.